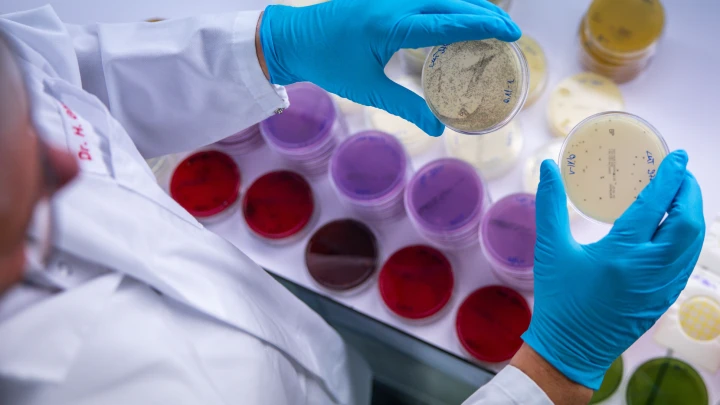

Учёные: Бактерии из кишечника попадают в мозг и лишают сна
Исследование ученых показало, что бактерии, попадающие из кишечника в мозг, могут воздействовать на сон
Учёные в очередной раз доказали, что микробиом играет важную роль в нормальном функционировании организма. В частности, он влияет на сон, а точнее ночной отдых могут нарушить бактерии, которые попадают из кишечника в мозг, сообщает "Новая наука".
Пептидогликан, компонент клеточных стенок бактерий в пищеварительной системе, может проникать в центральную нервную систему и влиять на поведение человека. В связи с этими данными ученые провели опыты на мышах, в результате которых им удалось установить изменяющиеся параметры пептидогликана в мозге в течение дня – минимальный уровень приходится на утренние часы.
Исследователи также отметили, что если животным не давать спать, то состав пептидогликана в разных отделах мозга отличается от обычного уровня. Кроме того, меняется активность генов. Ученые сделали выводы, что бактерии из кишечника вырабатывают вещества, влияющие на сон.
Уважаемые читатели Царьграда!
Если вам есть чем поделиться с редакцией Царьград Архангельск, присылайте свои наблюдения, вопросы и новости на наши странички в социальных сетях "Вконтакте", "Одноклассники", на наш "Телеграм-канал" или на электронную почту arhangelsk@tsargrad.tv.